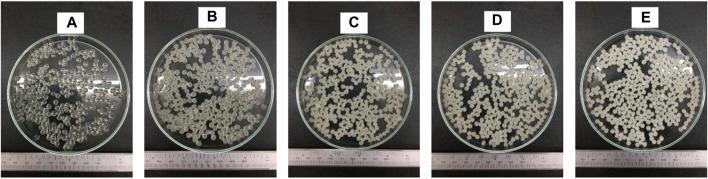

通过包封于果胶-抗性淀粉基水凝胶珠中实现菠萝蛋白酶的保护及胃肠道可控释放
Protection and Controlled Gastrointestinal Release of Bromelain by Encapsulating in Pectin-Resistant Starch Based Hydrogel Beads.
作者信息
Mala Thatchajaree, Anal Anil Kumar
机构信息
Food Engineering and Bioprocess Technology Program, Department of Food, Agriculture and Bioresources, School of Environment, Resources, and Development, Asian Institute of Technology, Pathum Thani, Thailand.
出版信息
Front Bioeng Biotechnol. 2021 Oct 29;9:757176. doi: 10.3389/fbioe.2021.757176. eCollection 2021.
Hybrid pectin and resistant starch-based hydrogel beads loaded with bromelain using the extrusion gelation method were prepared and evaluated to enhance the activity of bromelain during gastrointestinal passage and thermal processing. The solutions of pectin-resistant starch with bromelain were dropped into the gelation bath containing calcium chloride (0.2 M) solution to develop various types of hydrogel beads. The physicochemical characteristics of the synthesized hydrogel beads were evaluated. The ratio (4.5:1.5 w/w) of pectin and resistant starch concentration significantly ( < 0.05) enhanced the encapsulation efficiency (80.53%). The presence of resistant starch resulted in increased entrapment of bromelain, improved swelling properties with sustained release behavior, and improved gastric stability than pectin hydrogels alone. The swelling of hydrogel beads was higher at pH 7.4 than pH 1.2. Optimized batch of hybrid pectin/resistant starch exhibited a spherical shape. Optical and scanning electron microscopy showed a more packed and spherical shape from the pectin/resistant starch hydrogel bead network. Fourier transformation infrared spectroscopy was also used to confirm the presence of bromelain in the hydrogel beads. The encapsulated bromelain in the pectin/hi-maize starch beads produced at a pectin/hi-maize ratio of 4.5:1.5 (percent w/w; formulation P4) obtained the highest relative bromelain activity in all heat treatments including at 95°C, whereas the highest activity of free bromelain was found only at 30°C. Bromelain encapsulated in hydrogels released at a faster rate at simulated intestinal fluid (SIF, pH 7.4) than at simulated gastrointestinal fluid (SGF, pH 1.2).
采用挤出凝胶法制备了负载菠萝蛋白酶的果胶与抗性淀粉基混合水凝胶珠,并对其进行了评估,以提高菠萝蛋白酶在胃肠道消化过程和热加工过程中的活性。将含有菠萝蛋白酶的果胶-抗性淀粉溶液滴入含有氯化钙(0.2 M)溶液的凝胶浴中,制成各种类型的水凝胶珠。对合成的水凝胶珠的理化特性进行了评估。果胶与抗性淀粉浓度之比(4.5:1.5 w/w)显著(<0.05)提高了包封效率(80.53%)。抗性淀粉的存在导致菠萝蛋白酶的截留率增加,具有缓释行为的溶胀性能得到改善,并且比单独的果胶水凝胶具有更好的胃稳定性。水凝胶珠在pH 7.4时的溶胀度高于pH 1.2时。优化后的果胶/抗性淀粉批次呈现球形。光学显微镜和扫描电子显微镜显示,果胶/抗性淀粉水凝胶珠网络呈现出更紧密堆积的球形。傅里叶变换红外光谱也用于确认水凝胶珠中菠萝蛋白酶的存在。在果胶/高直链玉米淀粉比例为4.5:1.5(重量百分比;配方P4)时制备的果胶/高直链玉米淀粉珠中包封的菠萝蛋白酶,在包括95°C在内的所有热处理中均获得了最高的相对菠萝蛋白酶活性,而游离菠萝蛋白酶的最高活性仅在30°C时出现。包封在水凝胶中的菠萝蛋白酶在模拟肠液(SIF,pH 7.4)中的释放速度比在模拟胃肠液(SGF,pH 1.2)中更快。